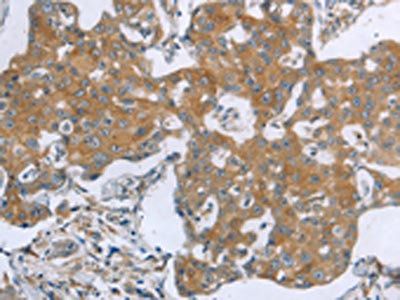
TNK2 Antibody

You have no items in your shopping cart.
Search results for: 'CDC42'
- Cdc42EP2 rabbit pAb [orb767346]Featured

ELISA, IHC-P, WB
Human, Mouse, Rat
Polyclonal
Unconjugated
50 μl, 100 μl - MRCKβ rabbit pAb [orb765693]Featured

ELISA, IHC-P, WB
Human, Mouse, Rat
Polyclonal
Unconjugated
100 μl, 50 μl - CDC42 Rabbit Polyclonal Antibody [orb592656]
IHC, WB
Human
Canine, Rabbit
Rabbit
Polyclonal
Unconjugated
100 μl